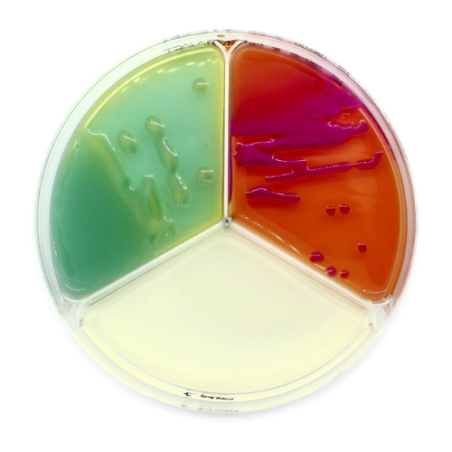

Sous-catégories
-
Milieux déshydratés
-
Milieux liquides

Milieux liquides
Découvrez notre sélection de nos produits de milieux de culture liquides.
-
Milieux précoulés